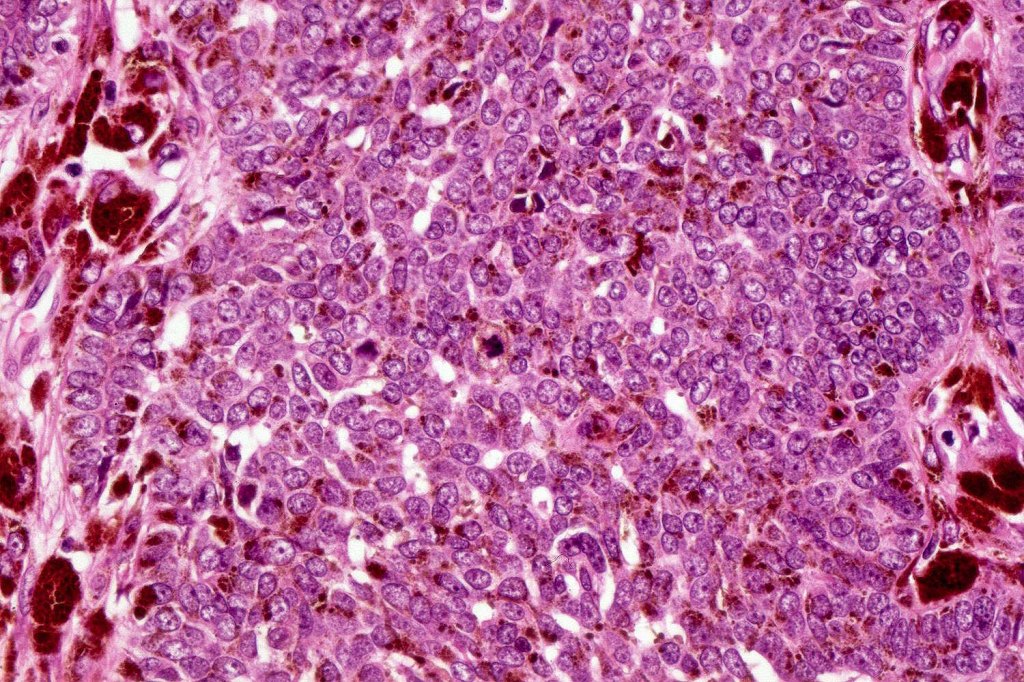
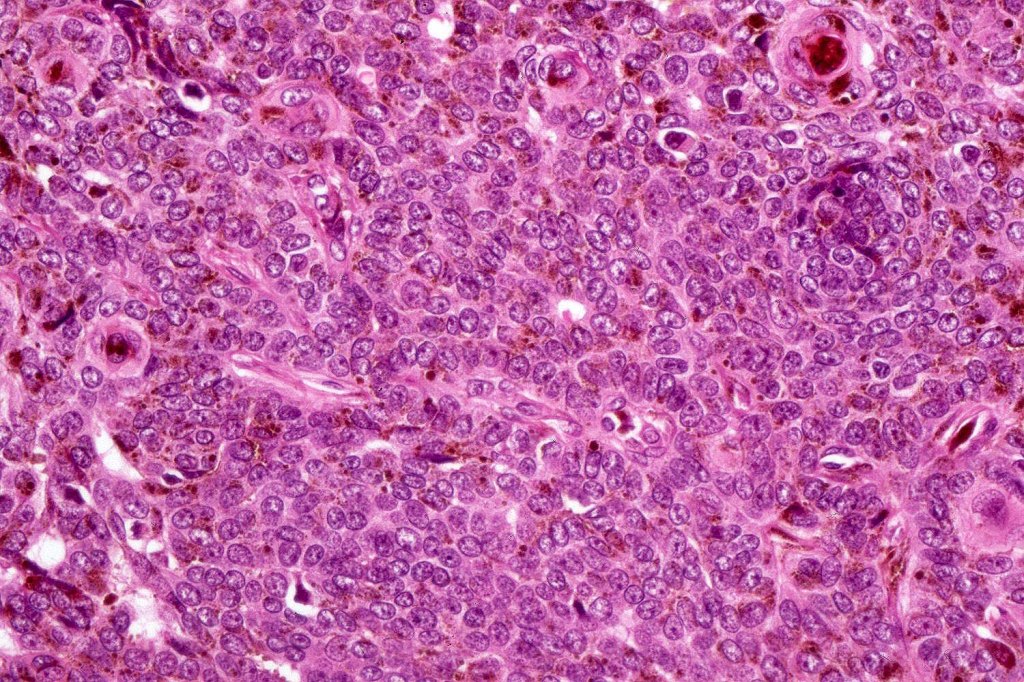

Clinical features
•Fairly common lesion present at birth or becomes obvious in the 1st 2 decades (0.3% of newborns)
•M=F
•No racial predilection
•Solitary yellow, waxy, circumscribed lesion up to 6.0 cm in diameter most often on the scalp or face although it can arise just about anywhere
•It characteristically enlarges & becomes warty during puberty & adulthood
•Linear & zosteriform variants
•Sometimes accompanied by verrucuous epidermal nevus
•Exceptionally associated with neurological symptoms (linear nevus sebaceus-, Schimmelpenning-Feurstein-Mims (Blaschloid nevus sebaceus, neurological, skeletal, cardiovascular, ophthalic & urological abnormalities)-, & SCALP (nevus sebaceus, CNS malformations, aplasia cutis, limbal dermoid & pigmented nevus) syndromes)
•Phacomatosis pigmentokeratotica (nevus sebaceus with speckled lentiginous nevus)

Histological features
•Deletion of PTCH gene & HRAS/KRAS mutations (it has been suggested that it represents a mosaic RASopathy
•Hamartoma characterized by abnormalities of epidermis, hair follicles, sebaceous glands, apocrine sweat glands & connective tissue
•Epidermis often papillomatous
•Follicular induction is common & sometimes trichoblastomatous foci are evident
•High, increased hyperplastic, sebaceous glands with openings onto the surface epithelium (in. old lesions, they may be absent)
•Reduced hair follicles
•Excessive numbers of apocrine glands
•May be complicated by a wide range of tumors (which are often multiple) including trichilemmoma, trichoblastoma, SCAP, sebaceous tumors, sweat gland tumors, melanocytic nevi & rarely by malignant tumors including BCC, SCC, melanoma, trichilemmal carcinoma, apocrine carcinoma & microcystic adnexal carcinoma

Leave a comment